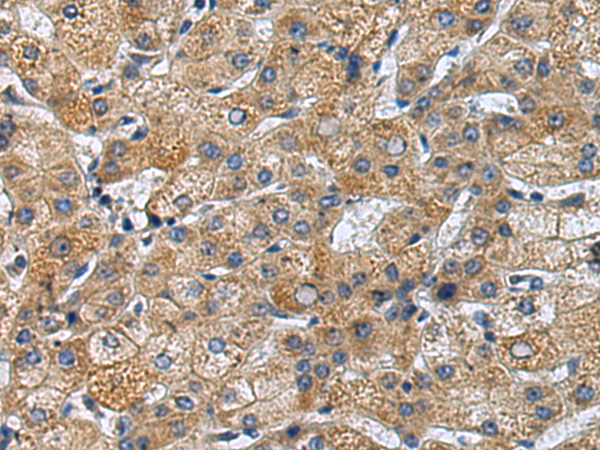

|
Background: |
May play a role in vesicular transport from endoplasmic reticulum to Golgi. |
|
Applications: |
ELISA, IHC |
|
Name of antibody: |
TRAPPC4 |
|
Immunogen: |
Fusion protein of human TRAPPC4 |
|
Full name: |
trafficking protein particle complex 4 |
|
Synonyms: |
SBDN; TRS23; PTD009; CGI-104; HSPC172; SYNBINDIN |
|
SwissProt: |
Q9Y296 |
|
ELISA Recommended dilution: |
5000-10000 |
|
IHC positive control: |
Human liver cancer and Human thyroid cancer |
|
IHC Recommend dilution: |
100-300 |

購物車
購物車 幫助
幫助
 021-54845833/15800441009
021-54845833/15800441009
